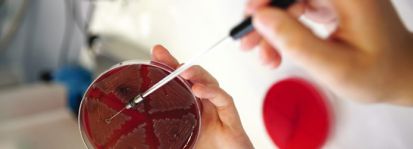

COME VISIT OUR NEW WEBSITE




Copyright © 2016 Spanish Snail S.L
Interested in our products


Manufacturer and supplier of raw materials
Cosmetics -Pharmaceutical - Food supplements

In 2014, with the aim of improving our product even further, we entered into a new research and development partnership with the (IRTA) institut d'investigació de la Generalitat de Catalunya. Today we are proud to offer to existing and potential clients a snail secretion product which meets the most demanding criteria interms of quality.
ABOUT
In pursuit of that priority, we established a programme of research, ran jointly with the Département de Génie Biologique (department of bio-engineering) of the Institut Universitaire de Technologie, Perpignan and the Laboratoire de Chimie des Biomolécules et de l’Environnement (LCBE, a research laboratory of the University of Perpignan).
Spanish Snail S.L



A series of microbiological and physico-chemical studies was carried out on snail secretion products which were available on the market at that time. Using the findings of this research, we then spent two years working on improvements to our own product.
At the end of that period, our companies, les jardins Christophe and Spanish Snail, were able jointly to apply for the following patents:
- a patent for the first snail secretion certified as organically produced Écocert,
Cosmos Standard (Cosmetic Organic Standard).
- a patent for the purification and stabilization of the active ingredients of snail
secretion, without the use of gamma, ozone, ultraviolet rays or preservatives.
The Spanish Snail company was created in response to a growing demand from laboratories for raw materials of the highest quality.
In order to achieve the objectives which we have set ourselves, we have drawn upon all our experience and knowledge to design products which will meet the requirements of the most demanding laboratories.
For each of our high-quality products, it is the application of our personal expertise, our extensive practical and technical experience, and our knowledge of various farming methods which distinguish us from our competitors.
We take great care to offer for sale only those raw materials and formulations over which we have complete control.
Our training in herbal medicine and herbal cosmetics at the IECAM (Instituto dos Estudos Culturais e Ambientais), Belo Horizonte, Brazil, has given us an understanding of indigenous communities' traditional knowledge and expertise in these fields. We have drawn upon this understanding in developing our own products.
In 2010 we decided to produce, on our own snail farm, snail secretion of high quality. From the outset, we made quality of the product our highest priority.



